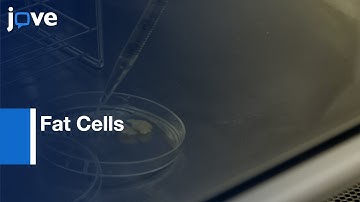
Dedifferenriated Fat Cells obtained | Protocol Preview

⬇ DOWNLOAD NOW
Kalau muncul iklan pop-up, tutup lalu klik tombol kembali
Download lagu Visualization Of 3D White Adipose Tissue Structure l Protocol Preview secara gratis hanya untuk keperluan promosi. Dukung artis favorit kamu dengan membeli musik original di iTunes atau platform resmi lainnya.
 Adipose Tissue Structure By Methylsalicylate Clearing & 3D Imaging l Protocol Preview
Adipose Tissue Structure By Methylsalicylate Clearing & 3D Imaging l Protocol Preview
 Human 3D Extracellular Matrix-Adipocyte Culture Model l Protocol Preview
Human 3D Extracellular Matrix-Adipocyte Culture Model l Protocol Preview
 Adipocyte, Fat Cells View in Microscope #shorts
Adipocyte, Fat Cells View in Microscope #shorts
 Human Mature Adipocytes: Membrane Mature Adipocyte Aggregate Cultures (MAAC) l Protocol Preview
Human Mature Adipocytes: Membrane Mature Adipocyte Aggregate Cultures (MAAC) l Protocol Preview
 Subcutaneous Fat in Females | 3D Anatomy Animation
Subcutaneous Fat in Females | 3D Anatomy Animation
 Hoe ontstaat vet in het lichaam? | Vetopslag uitgelegd
Hoe ontstaat vet in het lichaam? | Vetopslag uitgelegd
Dedifferenriated Fat Cells obtained | Protocol Preview
Dedifferenriated Fat Cells obtained | Protocol Preview
 The Secret Life of Fat Cells: Adipocytes #science #biology
The Secret Life of Fat Cells: Adipocytes #science #biology